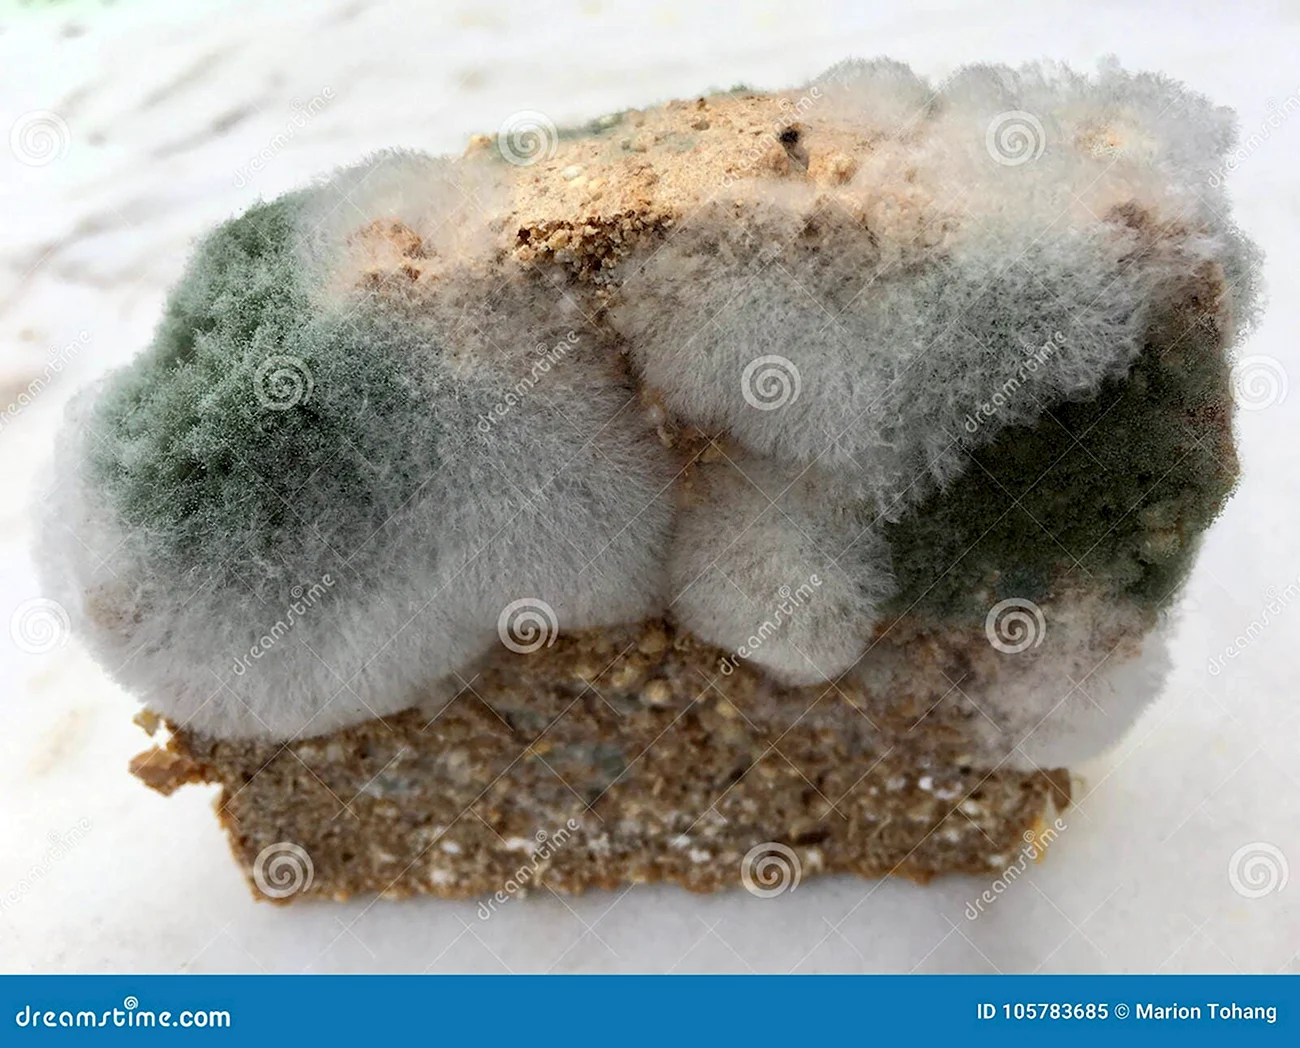

Привлекательная галерея фотографий, посвященная развитию плесени на хлебе, поразит своим разнообразием и качеством снимков. В ней собраны 55 уникальных фотографий и картинок, демонстрирующих яркие и характерные особенности плесневых колоний на поверхности хлеба. Если вас интересует окружающий мир микроорганизмов, присоединяйтесь, чтобы взглянуть на это удивительное явление. Просмотр этой галереи не оставит вас равнодушными!

Оцените картинки








Ничто так не добавляет пикантности обеду, как прикосновение плесени на свежем хлебе. Настоящий гурман не побрезгует таким деликатесом. А ведь и внешне так красиво выглядит, словно натуральная живопись на кусочке пшеничного дерева. Попробуйте, не пожалеете!
Ну вот, если хлеб вдруг стал арт-объектом, не спешите его выбрасывать! Каждая грибная крошка — это как маленький шедевр природы. Когда жизнь дает вам плесень, превращайте её в свой персональный музей современного искусства! В следующий раз вместо того, чтобы паниковать, попробуйте найти в этом что-то креативное. Кто знает, может, ваш завтрак станет новым трендом в мире гастрономии! ✨
Изображения плесени на продуктах вызывают отвращение и заставляют задуматься о важности правильного хранения пищи.
О, эти маленькие грибочки на хлебе – как миниатюрные художники, создающие свой уникальный мир! Кто-то мечтает о попугаях, а я вот в восторге от такого ‘модного’ дизайна!
Когда твой хлеб решил стать коллекционером искусства и начал создавать свои собственные шедевры!